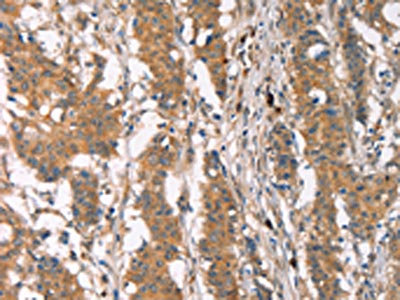

PLIN2 Antibody
-
中文名稱:PLIN2兔多克隆抗體
-
貨號:CSB-PA949559
-
規格:¥1100
-
圖片:
-
The image on the left is immunohistochemistry of paraffin-embedded Human liver cancer tissue using CSB-PA949559(PLIN2 Antibody) at dilution 1/30, on the right is treated with synthetic peptide. (Original magnification: ×200)
-
The image on the left is immunohistochemistry of paraffin-embedded Human gastric cancer tissue using CSB-PA949559(PLIN2 Antibody) at dilution 1/30, on the right is treated with synthetic peptide. (Original magnification: ×200)
-
Gel: 8%SDS-PAGE, Lysate: 40 μg, Lane: Mouse brain tissue, Primary antibody: CSB-PA949559(PLIN2 Antibody) at dilution 1/680, Secondary antibody: Goat anti rabbit IgG at 1/8000 dilution, Exposure time: 1 minute
-
-
其他:
產品詳情
-
Uniprot No.:
-
基因名:
-
別名:ADFP antibody; Adipophilin antibody; Adipose differentiation related protein antibody; Adipose differentiation-related protein antibody; ADRP antibody; MGC10598 antibody; Perilipin-2 antibody; PLIN2 antibody; PLIN2_HUMAN antibody
-
宿主:Rabbit
-
反應種屬:Human,Mouse
-
免疫原:Synthetic peptide of Human PLIN2
-
免疫原種屬:Homo sapiens (Human)
-
標記方式:Non-conjugated
-
抗體亞型:IgG
-
純化方式:Antigen affinity purification
-
濃度:It differs from different batches. Please contact us to confirm it.
-
保存緩沖液:-20°C, pH7.4 PBS, 0.05% NaN3, 40% Glycerol
-
產品提供形式:Liquid
-
應用范圍:ELISA,WB,IHC
-
推薦稀釋比:
Application Recommended Dilution ELISA 1:2000-1:5000 WB 1:500-1:2000 IHC 1:25-1:100 -
Protocols:
-
儲存條件:Upon receipt, store at -20°C or -80°C. Avoid repeated freeze.
-
貨期:Basically, we can dispatch the products out in 1-3 working days after receiving your orders. Delivery time maybe differs from different purchasing way or location, please kindly consult your local distributors for specific delivery time.
-
用途:For Research Use Only. Not for use in diagnostic or therapeutic procedures.
相關產品
靶點詳情
-
功能:May be involved in development and maintenance of adipose tissue.
-
基因功能參考文獻:
- Study utilizing THP-1 macrophages concludes that long-chain metabolite of vitamin E, alpha-13'-carboxychromanol, protects cells from lipotoxicity, at least partially via PLIN2 regulation. PMID: 29733984
- PLIN2 protein levels are significantly increased in patients with neoatherosclerosis. PMID: 29422264
- hese results suggested that PLIN2 may be considered a novel prognostic factor in Clear cell renal cell carcinoma (ccRCC) and a specific diagnostic indicator for patients with ccRCC. Furthermore, it could be a potential novel target for the clinical treatment of ccRCC PMID: 29749470
- ADRP knockdown significantly inhibited PDGFinduced increases in Vascular smooth muscle cell viability, caused G1 phase cell cycle arrest and decreased PCNA expression. PMID: 28713961
- this papet shows that adipophilin is a novel prognostic biomarker in clear cell renal cell carcinoma PMID: 28404922
- PLIN2 gene Ser251Pro missense mutation is associated with reduced insulin secretion and increased insulin sensitivity. PMID: 26443937
- Interference with PLIN2 and PPARalpha resulted in major alterations in gene expression, especially affecting lipid, glucose, and purine metabolism. PMID: 27308945
- This study shows that hepatitis C virus suppresses hepatic ADRP expression in infected patients and cell lines. Forcing the expression of miR-148a and miR-30a limits the suppressive effect of hepatitis C virus on ADRP. PMID: 27591428
- ADP was expressed in a small proportion of lung adenocarcinoma suggesting that ADP-positive lung adenocarcinoma could be a distinct subtype of lung adenocarcinoma, induced by up-regulation of the lipogenic pathway. PMID: 27467545
- Activation of ARF1 dissociates ADRP from lipid droplets. A constitute active form of ARF1 (ARF1Q71I) promotes HCV assembly. ADRP played a positive role in Hepatitis C virus replication and negative role in Hepatitis C virus assembly. PMID: 27157138
- PLIN2 expression is significantly upregulated in human masticatory mucosa during wound healing PMID: 28005267
- Adipophilin was present in 24 of 26 colorectal hyperplastic polyps, but did not correlate with presence of white opaque substance (i.e. lipid droplets) on magnifying endoscopy with narrow band imaging. PMID: 26636961
- Conserved amphipathic helices mediate lipid droplet targeting of PLIN1, PLIN2, and PLIN3. PMID: 26742848
- In hepatitis C virus -infected human livers, occludin and ADRP mRNA expression levels correlated with each other. Hepatitis C virus increases occludin expression via the upregulation of ADRP. PMID: 26731658
- PLIN2 involves lipid modulation of GSK3 activity, GSK3 substrate expression, and cell growth/survival. PMID: 26598603
- PLIN2 inhibits insulininduced glucose uptake by activating NLRP3, caspase1 and IL1beta, leading to a decreased IRS1 expression. PMID: 26166692
- Plin2 appears to be associated with functional alterations of the muscle PMID: 25559404
- Results demonstrate the clinical utility, specificity, and sensitivity of urine AQP1 and PLIN2 to diagnose renal cell carcinoma. PMID: 26181025
- Postprandial triglyceride rich lipoproteins may be involved in atherosclerotic plaque formation through the regulation of perilipin-2 and perilipin-3 proteins in macrophages. PMID: 25595097
- Immunohistochemical distinction of renal cell carcinoma from other carcinomas with clear-cell histomorphology: utility of CD10 and CA-125 in addition to PAX-2, PAX-8, RCCma, and adipophilin. PMID: 25279712
- ADRP was detectable in human BM during the whole 12 months of lactation period and its levels were intraindividually well-conserved. PMID: 24577896
- Perilipin 2 binding to the lipid droplet surface requires both hydrophobic and electrostatic interactions. PMID: 25172666
- Fat deposition within skeletal muscle in form of Plin2-coated lipid droplets increases with age and is associated with decreased muscle strength and thickness, likely through an IGF-1- and p53-dependent mechanism. PMID: 23977392
- Mammary analogue secretory carcinoma is a lipid-rich tumour containing large lipid droplets covered by adipophilin. PMID: 23931576
- Overexpression of ADRP alone increased the formation of foam cells and consequently autophagic activity. PMID: 24405744
- Data indicate that the allele of the missense polymorphism Ser251Pro disrupts a predicted alpha-helix in perilipin 2 (PLIN2). PMID: 23603836
- PLIN2 is the major perilipin regulated during sebocyte differentiation in vitro. PLIN2 is also important for sebaceous lipid accumulation in vitro and regulates sebaceous gland size in vivo PMID: 23688400
- Sprint interval and traditional endurance training increase net intramuscular triglyceride breakdown and expression of perilipin 2 and 5 PMID: 23129790
- Gene expression profile indicated a significant over-expression of the adipophilin gene and marked up-regulation of other genes involved in lipid metabolism in Burkitt lymphoma. PMID: 22952953
- Data suggest that prolonged endurance exercise training increases expression of perilipin 2 alongside increases in intramuscular triglyceride content specificly in type I/slow-twitch muscle fibers of type 2 diabetes patients. PMID: 22949030
- It was shown that the PLIN2 content in skeletal muscle is unchanged in response to a single bout of endurance exercise. The PLIN2-intramuscular triglyceride association was reduced postexercise. PMID: 22496505
- PLIN2-PLIN5 proteins were all more abundant in women than in men (p = 0.037 and p < 0.0001, respectively), consistent with higher intramyocellular lipid content observed in female skeletal muscle. PMID: 22667335
- High PLIN2 protein level is associated with colorectal cancer. PMID: 21828233
- The frequency of adipophilin-positive cases was significantly higher in apocrine breast carcinomas compared with nonapocrine carcinomas. PMID: 21566511
- Adipophilin-positive macrophage infiltration in the fibrous cap might be correlated with instability in neurological status PMID: 20887090
- Perilipin may play a role in the long-term storage of fat, which may be only partially reflected by cell culture models. PMID: 20661576
- Adipophilin can be valuable in an immunohistochemical panel when evaluating cutaneous lesions with clear cell histology PMID: 20118912
- Adipophilin augment inflammation in macrophages, which might be one role of adipophilin in atherosclerosis. PMID: 19851831
- ADRP upregulation mediated by retinol and palmitate promotes downregulation of hepatic stellate cells activation and is functionally linked to the expression of fibrogenic genes. PMID: 20143336
- Expression patterns of perilipin and adipophilin in nonalcoholic fatty liver disease livers vary with the size of lipid droplets PMID: 20032580
- Findings revealed an upregulation of ADRP during macrophages differentiation into foam cells. PMID: 19351497
- LXR, upon stimulation with GW3965, directly regulates human ADFP transcription by binding to LXR response elements located in the 3'-untranslated and the 5'-flanking regions PMID: 19843633
- induction by hypoxia PMID: 12387890
- targeting of the lipid droplet-binding adipocyte differentiation-related protein. PMID: 12591929
- Expression of adipophilin is enhanced during trophoblast differentiation and is up-regulated by ligand-activated PPARgamma/retinoid X receptor. May contribute to fatty acid uptake by placenta. PMID: 14671211
- Stimulation of adipophilin expression in macrophages by modified LDL promotes triglyceride & cholesterol storage and reduces cholesterol efflux. Adipophilin might contribute in vivo to lipid accumulation in the intima of the arterial wall. PMID: 14707038
- GDP-bound ARF1 induces dissociation of ADRP from the Lipid droplet surface;. PMID: 15336557
- TIP47 and adipophilin are components of many, but not all, the lipid droplets in THP-1 cells PMID: 15545278
- ADRP and TG regulate each other, and the ubiquitin-proteasome system is involved in degradation of ADRP during regression of lipid-storing cells. PMID: 16230742
- Data demonstrate that adipose differentiation-related protein (ADRP) mRNA and protein are regulated by fatty acids in a human placental choriocarcinoma cell line (BeWo) and in primary human trophoblasts. PMID: 16391323
顯示更多
收起更多
-
亞細胞定位:Membrane; Peripheral membrane protein. Lipid droplet.
-
蛋白家族:Perilipin family
-
組織特異性:Milk lipid globules.
-
數據庫鏈接:
Most popular with customers
-
-
YWHAB Recombinant Monoclonal Antibody
Applications: ELISA, WB, IHC, IF, FC
Species Reactivity: Human, Mouse, Rat
-
Phospho-YAP1 (S127) Recombinant Monoclonal Antibody
Applications: ELISA, WB, IHC
Species Reactivity: Human
-
-
-
-
-